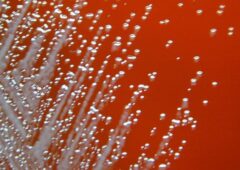
culture burkholderia pseudomallei

Première guérison du SIDA grâce à la greffe de cordon
C'est une nouvelle réjouissante sur le front de la lutte contre le sida. Après avoir reçu un traitement de pointe il y a quatre ans, une femme a visiblement vaincu le VIH et la leucémie.

Greffe d’un cœur de porc sur un humain réussie : pourquoi cet animal est-il un bon donneur ?
Un cinquantenaire américain atteint d'une maladie cardiaque a reçu le cœur d'un porc. Mais pourquoi cet animal est-il privilégié pour les transplantations ? Éclairage avec un chirurgien.

Movano Ring : cet anneau connecté veut surveiller les maladies chroniques
Le Movano Ring qui sera présenté au CES 2022 a des ambitions médicales. La société de technologie médicale du même nom espère que cet anneau pourra aider à surveiller les maladies chroniques au quotidien en…

Brosse à dents électrique ou manuelle : laquelle est la meilleure selon la science ?
Les brosses à dents électriques sont-elles plus efficaces que les brosses à dents manuelles ? Laquelle faut-il choisir ? Voici ce que les chercheurs ont découvert au travers de plusieurs études menées sur différentes parties…

Les bracelets et colliers anti-5G sont dangereusement radioactifs
Les personnes qui portent des bracelets et colliers pour « se protéger » des ondes émises par la 5G sont prévenues. L’Authority for Nuclear Safety and Radiation Protection vient d’annoncer que ces produits anti-5G sont…

Les AirPods 3 pourraient surveiller votre santé et prendre votre température
Apple serait en train de travailler sur des AirPods équipés de fonctionnalités liées à la santé. Les écouteurs sans fil seraient notamment capables de surveiller la posture de l’utilisateur, de détecter s’il a de la…

Un ophtalmologue utilise son iPhone 13 Pro Max pour examiner les yeux
Aux États-Unis, un ophtalmologue se sert de son nouvel iPhone 13 Pro Max au travail. Le mode macro de la caméra lui permet effectivement d’examiner les yeux de ses patients en prenant une photo à…

Pourquoi faut-il se laver les mains pendant 20 secondes ?
Le lavage des mains est l’une des solutions hygiéniques les plus efficaces et faciles pour lutter contre les bactéries et les virus. Une nouvelle étude s’est penchée sur la physique du lavage des mains pendant…
Une bactérie mortelle d’Asie du Sud réapparait sur le territoire américain et infecte quatre personnes
Aux Etats-Unis, une quatrième personne a contracté la mélioïdose, une maladie bactérienne infectieuse. Possiblement mortelle, elle est causée par une bactérie endémique d'Asie du Sud. Pourtant, aucun des patients n’avait séjourné dans ces régions.

Le succès est-il lié à la testostérone : une étude anglaise casse le mythe
Des chercheurs de l’Université de Bristol ont voulu vérifier si la testostérone avait bien un impact sur le niveau socio-économique des hommes. Des résultats publiés le 28 juillet suggèrent que les effets sont moins importants…

Covid-19 : 22 personnes sur 40 ont des symptômes neurologiques persistants
À la suite de l’infection à la Covid-19, certains patients développent ce qui est appelé le Covid long et qui se manifeste par plusieurs symptômes. Selon une nouvelle étude, des lésions nerveuses au niveau de…

De 125 à 132 ans, ce nouveau record de longévité humaine tombera avant la fin du siècle
L’Homme pourra vivre de plus en plus longtemps. Selon une nouvelle étude, la longévité humaine pourrait battre de nouveaux records dans les décennies à venir. Le 21e siècle verrait ainsi des âges qui n’ont encore…

Apple liste les appareils que vous devez éloigner de votre pacemaker
Apple vient de publier la liste de ses appareils que vous devez garder à distance de votre pacemaker ou de tout autre dispositif médical tel qu’un défibrillateur. Ces appareils Apple sont équipés d’aimants qui peuvent…

Coronavirus : des données retrouvées contredisent la version officielle de la Chine
Un scientifique de Seattle a découvert des fichiers supprimés d’une base de données contenant des séquences génétiques qui contredisent l’origine annoncée par le gouvernement chinois de l’épidémie de Covid-19.

Les cellules humaines peuvent convertir des séquences d’ARN en ADN
Un groupe de chercheurs de l'université Thomas Jefferson a apporté la première preuve que des segments d'ARN peuvent être réinscrits dans l'ADN.

L’Homme peut vivre 150 ans au maximum, affirment les scientifiques
L’être humain n’est pas près d’atteindre l’immortalité. Selon une nouvelle étude, des chercheurs estiment que l’humain peut vivre jusqu’à 150 ans, grand maximum. Au-delà de cet âge limite, rester vivant relèverait d’un miracle.

iOS 15 inclurait une nouvelle fonction de suivi des aliments
Nous ne sommes plus qu'à deux semaines de la WWDC 2021, où Apple annoncera les prochaines versions majeures d'iOS, watchOS, tvOS et macOS. Alors que peu de détails sur les mises à jour ont fuité…

Aveugle depuis 40 ans, il recouvre la vue grâce à la thérapie génique
Une première mondiale ! Après 40 ans de cécité, un homme aveugle atteint d’une maladie génétique dégénérative recouvre partiellement la vue grâce à une toute nouvelle thérapie génique liée à une stimulation lumineuse.

Tchernobyl : les survivants n’auraient pas transmis de mutation génétique à leurs enfants
Les survivants de la catastrophe nucléaire de Tchernobyl ne semblent pas avoir transmis de mutations génétiques dangereuses à leurs enfants. Deux nouvelles études sur les conséquences sanitaires de la catastrophe viennent de paraître.

Confinement 2021 : voir le rayon de 10 km à vol d’oiseau autour de chez vous
La France reconfine une partie de sa population. Les sorties détente restent possibles dans les 10 km autour du domicile. Voici comment vous pouvez visualiser vos sorties.

Couvre-feu 2021 : téléchargez ici votre attestation de déplacement
L'attestation de déplacement dérogatoire est de retour pour quelques millions de Français. Pour éviter toute amende, voici comment l'utiliser et où la télécharger.

Impression 3D médicale : une encre imprime des os dans le corps des patients avec des cellules vivantes
Des chercheurs ont mis au point une nouvelle technique d’impression 3D médicale qui consiste à imprimer des os directement dans le corps des patients à l’aide d’une encre céramique et de cellules vivantes, le tout…

Et si l’Apple Watch pouvait prévenir de l’insuffisance cardiaque ?
L’Apple Watch a d’ores et déjà fait ses preuves en sauvant la vie de plusieurs de ses utilisateurs. La montre connectée serait-elle capable d’aller encore plus loin en détectant les signes précoces de l’insuffisance cardiaque…

Quand la mort arrive-t-elle ? Des chercheurs ont étudiés les derniers souffles de vie
La mort ne commence pas au dernier battement de cœur. Le processus est en réalité plus complexe et plus long avec l’arrêt des différents organes. Des chercheurs ont donc étudié les derniers moments de vie…

Covid-19 : un homme s’est caché dans un aéroport pendant 3 mois pour se protéger du coronavirus
Aux États-Unis, un homme totalement terrifié de la Covid-19 a une idée incongrue pour éviter la contamination qui lui a valu de se retrouver face à la justice. Il s’est caché dans l’aéroport international O'Hare…

COVID-19 : Une étude démontre que les masques de protection bloquent 99,9% des particules flottant dans l’air
Cette étude insiste sur le fait que le port du masque réduit la possibilité d’inhaler les microparticules que nous rejetons de 99,9%. Cette pratique sauverait des vies et éviterait de nouvelles vagues de contamination de…
COVID-19 : un nouveau syndrome inquiétant affecte les populations déjà infectées
Des médecins ont identifié le syndrome de tachycardie orthostatique posturale (POTS) comme une séquelle de longue durée après avoir guéri du COVID-19.

Batman : ruiné par la pandémie, le justicier de Gotham fait un appel aux dons
Batman subit lui aussi les conséquences de la crise sanitaire. Dans une vidéo très rôle, le super-héros appelle la population à faire des dons pour l’aider à reprendre sa carrière de justicier de Gotham City.

Biloba, la consultation pédiatrique en ligne gratuite pendant une semaine
L’application Biloba vous offre la consultation pédiatrique en ligne pendant une semaine. Si vous avez une quelconque question médicale à propos de votre enfant, n’hésitez pas envoyer un message aux professionnels de santé.

Covid-19 : la perte de dents est une nouvelle conséquence à long terme du coronavirus
La Covid-19 est-elle aussi responsable de la perte de dents ? Selon un nouveau rapport, des patients ont souffert d’une perte de dents plusieurs mois après avoir été infectés. La liste des conséquences à long…
